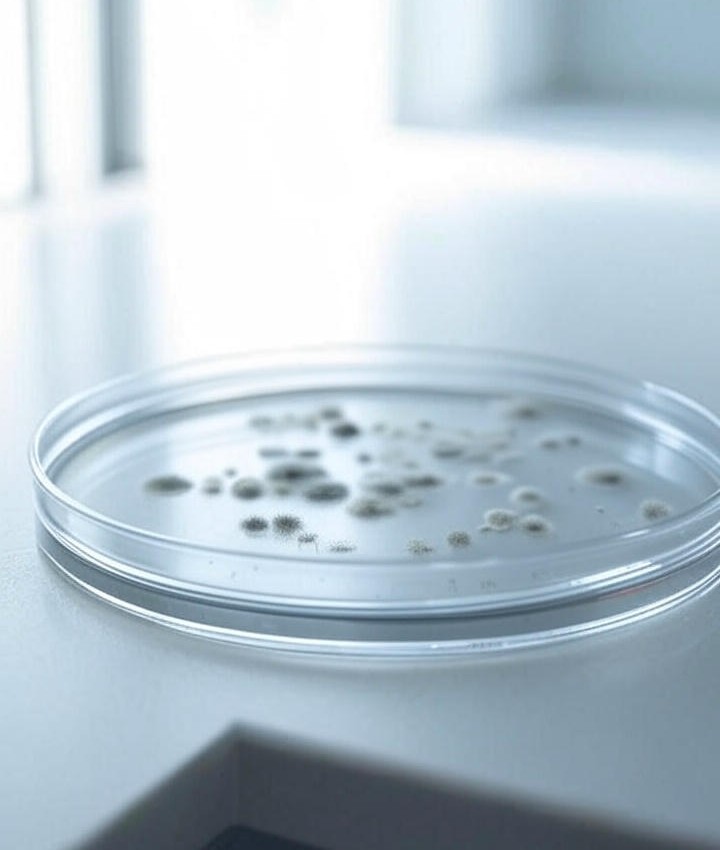

Ekspertyzy Mykologiczno-Budowlane
-
Jak realizujemy ekspertyzy mykologiczno-budowlane?
Oferujemy profesjonalne ekspertyzy mykologiczno-budowlane, oceniające stan budynków pod porażenia biologicznego grzybami, pleśniami oraz szkodnikami technicznymi degradującymi materiały budowlane. Jako członkowie Polskiego Stowarzyszenia Mykologów Budowlanych, stosujemy najwyższe standardy i zaawansowane metody badawcze. Wykonujemy specjalistyczne badania, obejmujące:
Próbki sedymentacyjne: pobieramy próbki z powierzchni i powietrza, hodowane w laboratorium przez około dwa tygodnie, aby zidentyfikować pleśnie i grzyby.Pomiary wilgotności: precyzyjne urządzenia określają poziom wilgoci w materiałach i powietrzu.Ocena stanu technicznego: sprawdzamy elementy konstrukcyjne pod kątem uszkodzeń spowodowanych wilgocią, takich jak korozja biologiczna czy osłabienie struktur.
Nasza usługa nie kończy się na dostarczeniu ekspertyzy. Oferujemy kompleksowe doradztwo w zakresie działań zapobiegawczych i naprawczych. Podpowiadamy, jak skutecznie wyeliminować przyczyny wilgoci, zapobiec ponownemu rozwojowi pleśni oraz poprawić jakość powietrza w budynku. W razie potrzeby koordynujemy dalsze kroki, takie jak profesjonalne osuszanie czy ozonowanie, aby zapewnić długotrwałe efekty.
